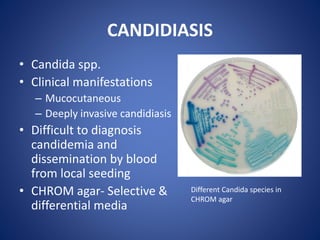
CANDIDIASIS
• Candida spp.
• Clinical manifestations
– Mucocutaneous
– Deeply invasive candidiasis
• Difficult to diagnosis
candidemia and
dissemination by blood
from local seeding
• CHROM agar- Selective &
differential media
Different Candida species in
CHROM agar

This document discusses the approach to systemic mycosis. It introduces common fungal pathogens that cause deep mycoses like Histoplasma capsulatum, Coccidioides immitis, and Candida species. It classifies mycoses anatomically, epidemiologically, and morphologically. It then describes specific mycoses like histoplasmosis, coccidioidomycosis, blastomycosis, cryptococcosis, aspergillosis, and mucormycosis in terms of their etiology, clinical manifestations, diagnosis and treatment. Investigations for systemic mycoses and antifungal treatment strategies are also summarized. A case example of cryptococcal meningitis